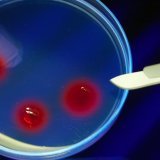
L'idée est de prendre de l'ADN de l'espèce éteinte et de comparer son génome à des espèces modernes proches. Une fois la plus proche sélectionnée, l'outil CRISPR, surnommé ciseaux moléculaires, est utilisé afin d'éditer le génome moderne, là où il...

Culture
Votre publicité ici ? Contactez-nous !
Une étude montre comment faire revivre une espèce éteinte de rat
Depuis le film Jurassic Park, l'idée de ramener à la vie des espèces éteintes fascine. Une équipe spécialisée dans la paléogénétique a cherché à déterminer la méthode qui permettrait de ressusciter une espèce de rat, le Rattus macleari.
Difficile de cerner l'ampleur du GHB en Suisse romande
Le GHB circule en Suisse romande, même s'il est difficile d'en déterminer précisément l'ampleur. Une étude a mis en évidence un cas de soumission chimique en 2021. Trop souvent, les prélèvements sont réalisés trop tard pour détecter la drogue du violeur.

Festi'neuch dévoile l'affiche complète de sa 21e édition
Festi'neuch dévoile l'affiche complète de sa 21e édition qui se tiendra du 9 au 12 juin, après deux ans d'absence, Covid-19 oblige. Outre Julien Doré, Véronique Sanson et Grand Corps Malade, le festival annonce encore L'Impératrice, Yard Act et Tshegue.

La Fondation Sion Violon Musique récolte 10'000 francs après un concert caritatif pour l'Ukraine
Un concert caritatif a eu lieu samedi dernier à Sion. Il a permis de récolter 10'000 francs en faveur de la population ukrainienne.

Découverte de l'épave de l'Endurance, le navire d'Ernest Shackleton
L'épave de l'Endurance, le navire d'Ernest Shackleton brisé par les glaces en 1915 au large de l'Antarctique, a été découverte dans la mer de Wedell par 3000 mètres de fond, ont annoncé mercredi ses découvreurs.

Le Conseil fédéral et le Parlement s'engagent pour la Lex Netflix
Les Suisses diront le 15 mai prochain s'ils veulent qu'environ 18 millions de francs soient versés chaque année au cinéma helvétique via les plateformes de streaming. Le conseiller fédéral Alain Berset est venu défendre la Lex Netflix devant la presse mardi.

Marius Bear chantera "Boys Do Cry" pour la Suisse à l'Eurovision
L'Appenzellois Marius Bear représentera la Suisse à l'Eurovision en mai à Turin (I). Un jury international et un panel de téléspectateurs ont désigné sa chanson "Boys Do Cry" ("Les garçons pleurent"), une chanson lente qu'il interprète avec sa voix profonde et rauque.

L'artiste Afra Kane nous présente son nouvel album 'Hypersensitive' et quel album !
Une bien belle découverte ! Afra Kane c'est une voix, c'est du talent et c'est un premier album 'Hypersensitive'. Ses ingrédients de la Soul, du Gospel, de la Musique Classique, une pointe de jazz. Un fabuleux cocktail à consommer sans modération !

Dans nos oreilles, le dernier album du rappeur suisse Stress 'Libertad'
Trois après 'Sincèrement', l'artiste rappeur Stress est de retour dans les bacs avec un nouvel album 'Libertad', 14 titres. La plume de Stress est libre comme l'air et son inspiration ne se limite pas au hip-hop, preuve en est une magnifique collaboration avec un orchestre symphonique.

Par crainte des bombes, Lviv tente de protéger son patrimoine
Elles sont le témoignage de la guerre qui s'approche. Dans le centre de Lviv, dans l'ouest de l'Ukraine, les innombrables statues sont désormais enveloppées de mousse, de bâches protectrices et de tissus anti-feu pour les protéger d'une éventuelle attaque.

